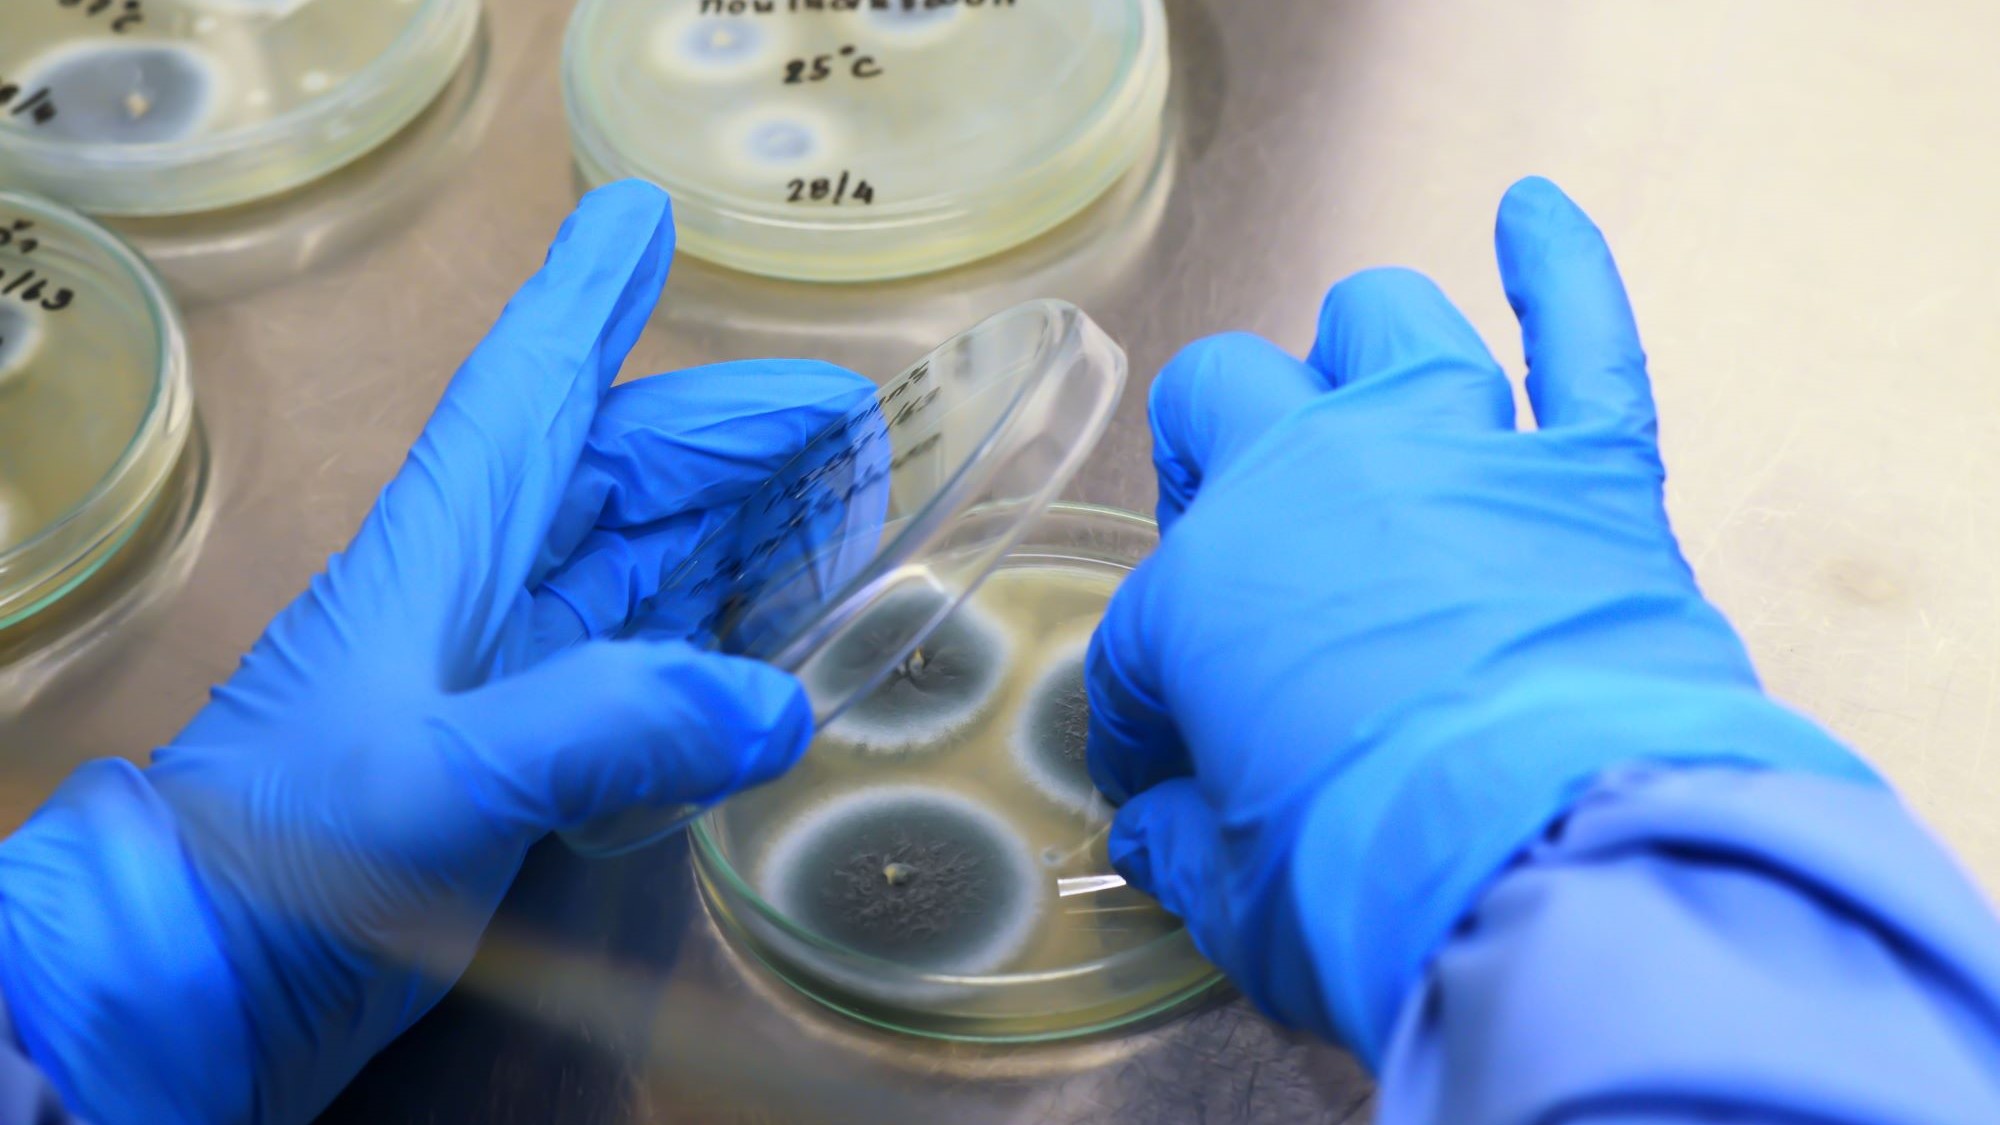
Foto: Shutterstock

Vriesdrogen minder energieslurpend: interessanter voor meer ingrediënten?
Het grote nadeel van vriesdrogen als conserveringstechnologie is dat het traditioneel een vrij duur en energie-intensief proces is. Vriesdrogen is voor voedingsbedrijven vaak een premiumkeuze: iets wat je reserveert voor batches waar de hoogste kwaliteit voor noodzakelijk is. Maar de ontwikkelingen staan niet stil. Zuinigere technologie maakt vriesdrogen toegankelijker.